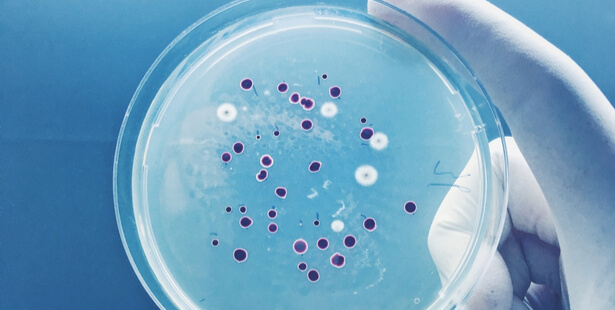

Ne confondez pas virus et bactérie !
Quand les antibiotiques stoppent la prolifération des bactéries, il faut en revanche trouver un vaccin pour combattre les virus en tous genres.

Qu’est-ce qu’une bactérie ? Qu’est-ce qu’un virus ? En ces temps de pandémie, une petite séance de révision s’impose…
La (toute) petite vie des bactéries
Les antibiotiques, ce n’est pas automatique ! Cette petite phrase didactique est restée dans toutes les têtes. Il ne servent en effet pas à tout soigner. La preuve : pas moins de onze vaccins sont désormais obligatoires, contre trois précédemment, depuis le plus jeune âge. Et la pandémie de coronavirus actuelle fait que l’on aura jamais autant entendu parler de santé, de vaccin et en l’occurrence des virus et de leurs mutations.
Pour autant, attention à bien savoir de quoi l’on parle et à ne pas tout confondre, notamment virus, bactéries et microbes. Ce dernier terme, inventé au 19ème siècle par un chirurgien français, Charles-Emmanuel Sédillot, signifie littéralement « petite vie ». Il qualifie tout être vivant que l’on ne peut observer qu’au moyen d’un microscope. Les bactéries en font partie et tirent leur nom du grec bakteria, les premières observées ayant une forme de bâton, quand la plupart sont en fait en forme de bille.
Des bactéries pathogènes ou bien utiles
Mais qu’est-ce qu’une bactérie ? C’est un être vivant microscopique, un microbe, aussi bien bénéfique que nuisible, selon les cas. Ces entités biologiques autonomes mesurant de 1 à 10 microns sont en fait monocellulaires, c’est-à-dire constituées d’une unique cellule entourée d’une paroi et dépourvues de noyau. Première forme de vie apparue sur notre planète il y a des milliards d’années, elles sont partout et peuvent aussi bien être au service de notre organisme, notamment pour digérer au sein de notre flore intestinale, que pathogènes, causant des angines, la tuberculose voire la peste ou le choléra. C’est justement à stopper la multiplication des bactéries que servent les antibiotiques.
Lire aussi : un savon antibactérien fait maison
Et les virus ? Leur nom est des plus explicites quant à leur dangerosité : cela signifie « poison » en latin ! Vingt fois plus petit qu’une bactérie, soit 20 à 500 nanomètres, le virus cherche à survivre et à se multiplier en envahissant, en trouvant une façon d’entrer dans les cellules hôtes au sein desquelles il pourra se répliquer. Le coronavirus actuel, le Covid-19, en est un exemple désormais connu de tous… Grippe, rage, polio et plus récemment Sida, on peut hélas en recenser les dégâts au fil des époques. Et, contre eux, les antibiotiques ne servent strictement à rien. Ils n’auront aucun effet sur eux. D’où la nécessité de chercher un vaccin, une méthode l’empêchant de s’immiscer dans les cellules pour s’y répliquer.
Comment combattre les virus à ADN ou ARN

Du fait des moyens importants déployés on a pu créer un vaccin à ARN messager, un principe connu depuis des dizaines d’années – © Cryptographer
Comment les combattre ? C’est là où l’on entre dans les vaccins de nouvelle génération développés à une vitesse historique pour combattre l’épidémie de Covid-19. Un virus est constitué d’un ADN ou d’un ARN (acide ribonucléique) entouré d’une structure protéique, la capside et parfois d’une enveloppe. Quand la varicelle, l’herpès ou l’hépatite B sont des virus à ADN, la grippe, la rougeole, l’hépatite C, la rage ou les coronavirus sont en revanche des virus à ARN. Un fonctionnement connu depuis des décennies.
Avec les vaccins à ARN messagers actuels, au lieu d’administrer au patient un agent infectieux atténué ou inactivé ou bien certaines de ses protéines, qui ne nous rendent pas malades mais entraînent notre organisme à se défendre contre cette menace, on laisse nos cellules fabriquer elles-mêmes le composant contre lequel notre organisme doit savoir se défendre. Une solution à la fois plus simple et plus rapide à produire que les composants des vaccins « classiques, » mais devant être conservée à une température extrêmement basse, les molécules d’acide ribonucléique étant particulièrement fragiles.
Illustration bannière : Différence entre virus et bactérie – © NatalieIme
A lire absolument